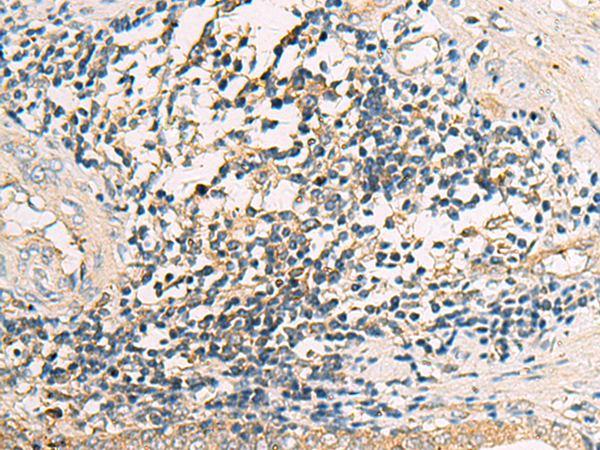

中文名稱:兔抗ASB10多克隆抗體
|
Background: |
The protein encoded by this gene is a member of the ankyrin repeat and SOCS box-containing (ASB) family of proteins. The SOCS box serves to couple suppressor of cytokine signaling (SOCS) proteins and their binding partners with the elongin B and C complex, possibly targeting them for degradation. Multiple alternatively spliced transcript variants have been described for this gene. |
|
Applications: |
ELISA, IHC |
|
Name of antibody: |
ASB10 |
|
Immunogen: |
Fusion protein of human ASB10 |
|
Full name: |
ankyrin repeat and SOCS box containing 10 |
|
Synonyms: |
GLC1F |
|
SwissProt: |
Q8WXI3 |
|
ELISA Recommended dilution: |
5000-10000 |
|
IHC positive control: |
Human prostate cancer |
|
IHC Recommend dilution: |
25-50 |
購物車
購物車 幫助
幫助
 021-54845833/15800441009
021-54845833/15800441009
